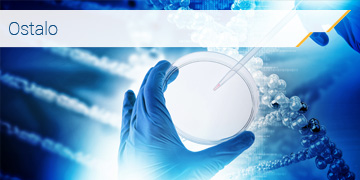
Alfa Genetics Reagents

Service
As an authorized distributor, importer, and certified service provider of renowned European brands, Alfa Genetics offers top-notch equipment, reagents, and consumables for use in laboratories in the fields of science, research, medicine, and diagnostics.

Equipment for Working with Liquids
Automated pipetting systems
Mechanical variable automatic pipettes
Mechanical fixed automatic pipettes
Electronic – digital pipettes
Manual dispensers – Multipette
Manual pipettor – serological
Bottle dispensers
Digital burettes – titrators
Peristaltic pumps

Equipment for Working with Cells and Cell Cultures
CO2 incubators
Thermo-shakers
Shaker-incubators
Micromanipulators
Microinjectors
Electroporators
Bioreactors
Bioreactors

Equipment for Sample Preparation and Processing
Centrifuges
Concentrators
Mixers and thermo-mixers
Thermostats and thermo-blocks
Magnetic stirrers
Shakers, rockers, rotators, vortexes
PCR machines and Real Time PCR machines
Digital PCR
Spectrometers and photometers
Electrophoresis systems
Microplate Readers & Washers
ELISA readers
Western blot and gel imaging systems
Gel photo-documentation systems
UV instruments & protective equipment
Ultracentrifuges

Equipment for Storage, Preservation, and Cryopreservation
Refrigerators and freezers
Combined refrigerators and freezers
Ultra-low temperature freezers
Blood storage devices
Portable refrigerators
Cryo preservation containers for biological samples
Containers for easy use of small amounts of liquid nitrogen
Containers for storage and transport of liquid nitrogen
Pressure vessels for dispensing and storing liquid nitrogen
Transportation containers for biological samples
Containers designed for dermatological applications
Freezing speed control for all types of samples
Temperature monitoring tools
Liquid oxygen reservoirs
Protective equipment

Laboratory Consumables
Autoclave bags for biological waste
Boxes for biological waste disposal
Laboratory filtration systems
Microtiter plates with 94/48/24/12/6 wells
Boxes for sample storage and preservation
Transfer pipettes – Pasteur pipettes
Autoclavable boxes for tips
Tips for automatic pipettes
Microtubes – Eppendorfs
Centrifuge Falcon tubes
Centrifuge tubes
Serological pipettes
Petri dishes

Laminar flow and UV cabinets
Laminar flow cabinets with vertical airflow
Cytostatics dissolution cabinets
Class II Biosafety cabinets
PCR chambers with UV air recirculators
Reagents for research that meet almost all requirements of scientific researchers:
Isolation and purification of biomolecules
Electrophoresis
Enzymology
Microscopy
Epigenetics
Gene expression and miRNA research
Genotyping
Next-Gen sequencing
Proteomics


















